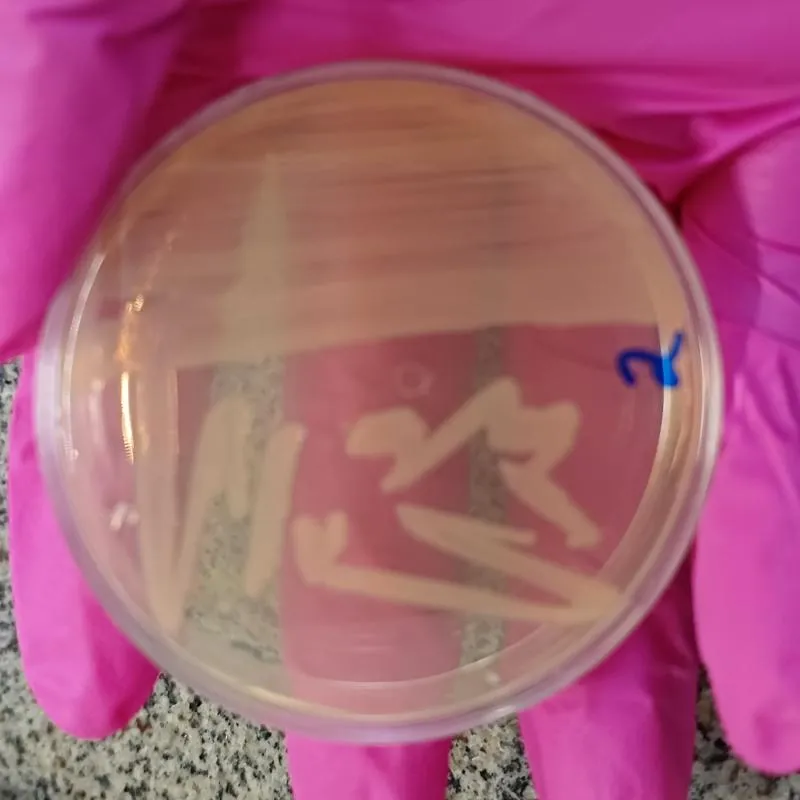
Imagem da campanha Rifa para pagamento da minha faculdade

Esta campanha não está ativa.
Rifa para pagamento da minha faculdade
Organizado por Laryssa Miranda
ver campanhas
Sorteio
24/03/2025, 00:00
Bilhetes por apenas
R$2,00
Toque nos botões para filtrar números 👇
Nenhum bilhete encontrado.
Descrição Confira o regulamento.
✅As cotas são liberadas após o pagamento.
📅 A Data do sorteio será divulgado quando obter 70% das cotas vendidas.
Boa sorte a todos 🍀
Meio de Pagamento:
Precisa de ajuda?
PLATAFORMA GRATUITA
Crie sua própria rifa online grátis!
Comece agora mesmo, sem tirar nada do bolso. Divulgue para milhares de pessoas e gerencie tudo em um só lugar.
100% gratuito
Sem taxa de adesão
Pagamento via Pix